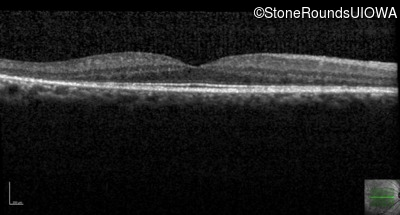
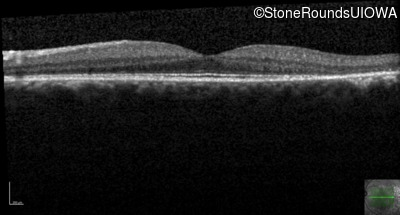
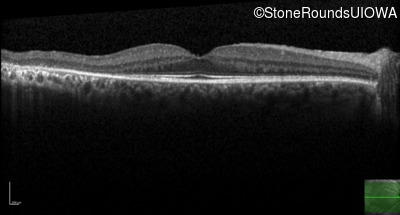
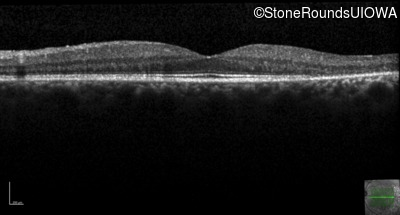
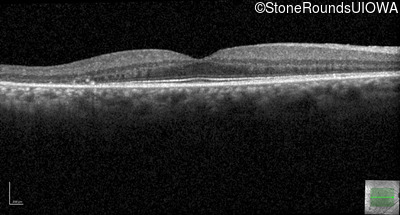
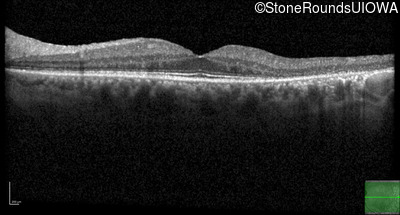

Case
SR207
Student Mode
AD Retinitis Pigmentosa (IA1aii)
Male
Male
Hidden
SR207
Student Mode
AD Retinitis Pigmentosa (IA1aii)
Male
Male
History
This 58 year old completely asymptomatic man had pigmentary changes on his last retinal exam.
| Age at visit: 66 years |
| Age at visit: 68 years |
Diagnosis & molecular findings
| Disease | Gene | Allele 1 variant(s) | Allele 2 variant(s) | Inheritance mode |
|---|---|---|---|---|
| AD Retinitis Pigmentosa | RHO | Gly3Asp GGC>GAC | AD |